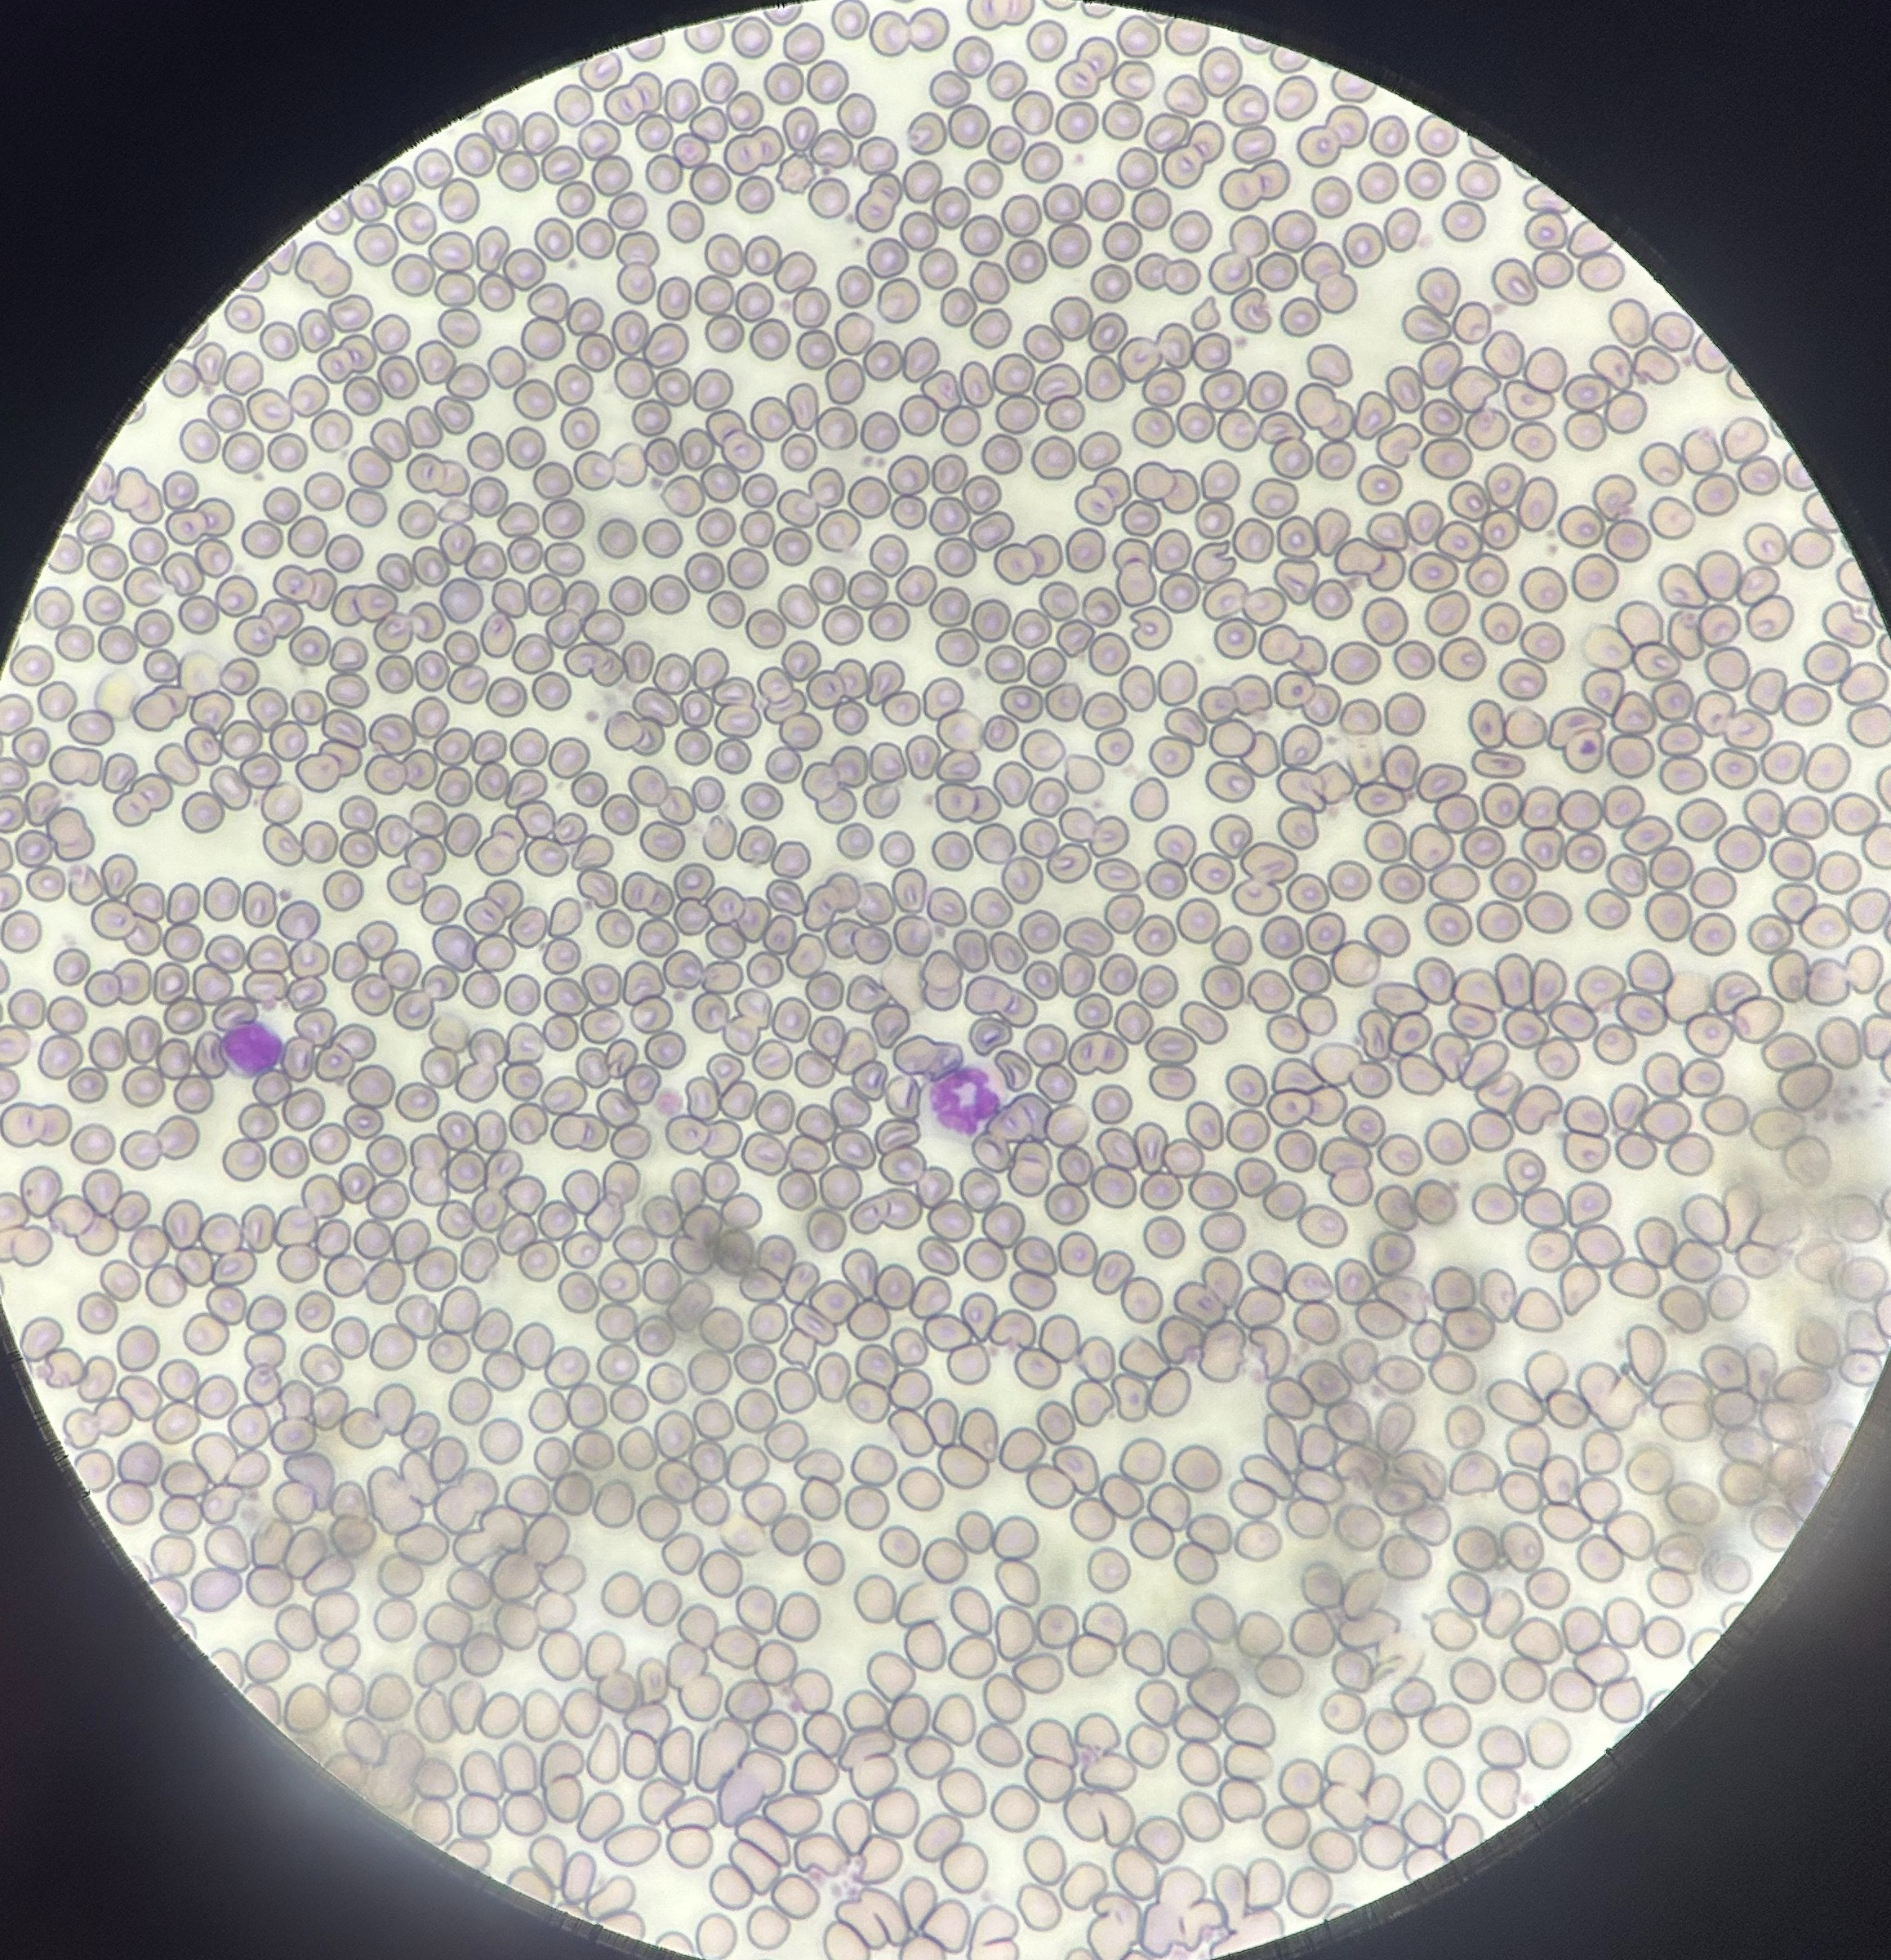
8D8463A1-4683-46D8-B2BC-D04FD1892273

7月11日(金)午後6時半から8時半まで、本校において小中学生とその家族を対象に天体観測会を実施しました。このイベントを始めてから3年目になりますが、徐々に知名度が上がっているようで募集を開始してからわずか3日で定員を大幅に上回る申し込みがありました。ありがとうございます。
生徒スタッフと何度も打ち合わせを行い、当日の準備を済ませました。しかし、残念ながら天候は曇りでした。6時半から7時半まで、校舎内の大会議室で星座早見盤の工作や天体に関する話などを行いました。外はすっかり暗くなりましたが空は曇ったままです。そんなとき天頂に一番星が見えました。牛飼い座のアークチュルスです。他の星も見えないか、参加者とスタッフ一同が一斉に探し始めました。すると、こと座のベガ、北斗七星の一部、わし座のアルタイルなどが見つかりました。春の大曲線が見つかり、おり姫とひこ星も無事にランデブーできて何よりです。
次回は8月下旬、そして12月にも実施する予定です。またお越しください。
7月9日(水)、応用数理科107HR生徒たちに対し、園瀬川総合科学調査の事前研修を行いました。事前研修では、まず川幅や流速などの測定方法を説明しました。その後、水生生物の採取法を教えると共に、「カゲロウの幼虫」や「カワゲラ」などの指標生物の説明に加えて、園瀬川に多く生息する「ハグロトンボのヤゴ」や「ヒゲナガトビケラ」の形態と生息場所について説明しました。最後に、「水の成分分析をしよう」として、用意した様々な水溶液に対し、パックテストを実施し、それぞれの成分測定を行いました。


7月11日(水)午後、応用数理科1年生によって園瀬川総合科学調査を実施しました。「上流」「中流」「下流」3か所の調査場所に分かれて調査を行います。主な調査内容は「流速の計測」「透明度調査」「岩石調査」「水質パックテスト」「水生生物の採取並びに指標生物を用いた水質調査」です。川での調査に生徒たちは童心に帰り、楽しんでいました。特に水生生物の採取では、事前学習の効果もありどんどん川に入っていき、多くの水生生物が採取できました。種の同定は指標生物表を用いると共に、載っていない種についてはグーグルレンズを用い行いました。「下流」では指標生物の測定では、やや汚れた川、パックテストの結果ではきれいな川との結果になりました。実際に見て、感じる学習であるフィールドワークや実験等の主体的な学びを経験し、科学的なものの見方や考え方を育みたいと思います。





パックテストを行います 多くの生物を採取しました。同定を行い、指標生物による水質を調査します
7月4日(金)午後から、徳島文理大学薬学部を訪ねました。生徒の課題研究において欠かせない分析があり、それを行うための前処理をするためです。今回は応用数理科だけでなく普通科の生徒も参加しました。研究室は建物の11階にあり、高所から眉山や吉野川がよく見えました。
サンプルとして採取した土壌をプラ製のシャーレに入れ、ふたをして乾燥機に入れます。また、同時に採集してきた植物をきれいに洗浄して、これを薄くスライスしてシャーレに載せます。これも同じ乾燥機に入れてしばらく待ちます。ところが、乾燥までに4時間かかる間は手持ち無沙汰になる上に、機器の操作が高校生には難しいということから今日はここまでになりました。また後日に伺う予定です。
研究を進めていくと、どのような結果が出て今後にどのように影響を与えるのか、期待と不安でいっぱいになります。でもそこにこそ研究の醍醐味があるように感じられます。
6月27日(金)6、7限目に応用数理科107HRにおいて、ScienceIntroductionの授業で、徳島大学pLEDフォトニクス研究所から、時実 悠 先生をお招きして高大連携授業を実施しました。
最初は研究者になった経緯と現在の研究、そのやりがいについて自己紹介と合わせて、説明していただきました。研究者になった経緯では、大学見学に行った際、「大人が一生懸命取り組んでいることに面白い」と感じ、研究者を目指されたそうです。、また、研究と学習について「答えが分かっている問いかどうか」「分かってないことを分かることが面白い」というお話しをしていただきました。


ご自身が行っている研究は「光りを使った計測」だそうです。例を上げ、分かりやすく説明していただきました。
最後は、実際にレンズの公式を使った実験を行いました。高校受験にも良く出題される、光源、レンズ、スクリーンを使い、はっきりと像を結ぶ位置を測定し、蛍光灯の明かりでは、どうなるのか考えました。


光源からの距離が遠くなると、レンズからスクリーンまでの距離がとても短くなることが分かり、小学生の頃、太陽を虫眼鏡で光りを集めていた現象は、「太陽そのものを写していた(向きは上下左右逆です)」ことを説明していただきました。身近な現象が科学的に分析されることは、とても面白いことだと感じました。
本物と出会うことで、自然現象が科学的な見方から見る力が養われる。ぜひ、よい気付きを生む機会をどんどん提供していきたいです。
6月24日(火)13:30から徳島文理大学薬学部を訪問させていただき、AdvancedScience 生物専攻 の授業として、応用数理科3年生を対象に高大連携授業を行いました。
授業は、「血球と生体防御」をテーマに講義と実習行いました。最初は講義していただき、様々な血球の説明や好中球やその他の食細胞の働き、さらに好中球の特徴である分葉核は、血管壁等をすり抜けるためのものであることを説明していただきました。
その後、マイクロピペット等を使い、血液飛沫標本を作製し、メイグリュンワルド・ギムザ染色により血液細胞を染色し、顕微鏡で観察しました。さらに、細菌感染させたマウスの筋組織の切片を作成し、細菌感染により変形した筋組織や細菌を排除しようとして好中球が集まっているところを観察しました。


血液飛沫標本を作製しています 顕微鏡で観察しています
生徒たちは、実際にマウスの血球を見て、好中球を見つけるのに一生懸命でした。実際に手を動かし、考え、学ぶ、大学の本格的な学びに少し触れることが出来たでしょうか。高校での学びと大学での学びをつなげることで、生徒の主体的な学びを推進し、科学的な見方考え方を育成していきたいです。

マウスの病気の筋肉に好中球(紫の細胞)が集まっています 血球のほとんどは核を持たない赤血球ですが・・・
6月25日(水)13:00~社会科教室にて、応用数理科2年生が「理数探究」で実施している課題研究の中間発表Ⅰがありました。第一回目の発表であり、まだまだ予備実験等の段階ではありますが、結果のまとめや考察について、担当教員と一緒に考え、発表スライド・発表原稿を作成できました。
今年度は徳島文理大学との連携が始まり、関わり方の大小はありますが、計5グループが指導や分析機器等をお借りしながら進めています。
高大連携の活用により例年と比べ、実験が進んでいるグループが増えたとかんじました。
まだまだ、発表に自信がなく、まとめや考察に関しても十分ではないですが、発表会を経験してくことで、自信を持って発表や質疑応答が行えるようになります。課題研究における一連の経験で論理的思考力が育成され、問題解決能力、プレゼンテーション能力、実験計画能力やコミュニケーション能力が向上されると考えます。我々教員も一生懸命サポートします。ぜひ、応用数理科での経験から課題を見いだし、解決方法を考える力を身に付けて欲しいと思います。


今年度の研究班は11班で、発表テーマは以下の通りです。
生物分野:放線菌における代謝物の成分及び機能について(文理大連携)、トリプタンスリンの抗菌活性効果について(文理大連携)、アオサノリの養殖に向けて(文理大連携)、ミジンコの突起の形成を引き起こす要因、ゴキブリの光走性とその学習効果
地学分野:かんむり座T星の観測徳島における
化学分野:PFASの残存量(文理大連携)、にし阿波の土と野菜のミネラルを調べる(文理大連携)、海部刀研究Ⅲ〜刀剣の成分を調べる〜、匂いと濃度の関係
物理分野:効率の良い集音モデルを考える、かまぼこ板に働く現象
関わりの大小ありながら、文理大連携グループが増えてきました。高大連携を活用した課題研究の推進を進めていきたいと思います。
6月17日(火)~6月21日(土)以前SSH海外研修で訪問していたSanFsrancisco Sacred Heart Cathedral Preparatory(以下SHCP)校の生徒・先生が本校を訪問し、一緒に授業受講しました。さらに事前に、ホストファミリーを募集し、SHCPの生徒達はこの間、本校生徒の家にホームステイを行いました。
6月17日(火) 本校ホストファミリー生徒とSHCPホームステイ生徒が交流し、今後の計画を立てました。ホストファミリー生徒はバディとなり、SHCP生徒の授業受講のサポートを行います。
その後、体育館にて全校生徒で歓迎会を行いました。


ホストフェミリーとホームステイ生徒と交流です 体育館で歓迎会を行いました
6月18日(水)19日(木)は一緒に授業を受講しました。城南高校の先生方も工夫していただき、ポイントを英語で講義したり、SHCP生徒と一緒に楽しめるイベントを企画したりしていただいて、本校生徒にもとてもいい経験になったと感じました。


6月20日(金)は、今年度から徳島県に導入されたラーケーションを活用し、ホストフェミリーがSHCP生徒と一緒に徳島県の観光名所等を訪れました。鳴門の渦潮を見に行ったり、祖谷のかずら橋を訪れたりと非常に楽しい経験になったみたいです。、また、夜には花火をしたり、流しそうめんをしたりと、思い出に残る一日となりました。
6月21日(土)は本校に集合し、バスで関西国際空港に帰るSHCP生徒達をお見送りしました。最後は、涙のお別れで、非常に深い交流になったと感じました。SHCP生徒は「次年度も来るよ」「San Fsranciscoに来て、ホームステイをしてね」との話をして、お別れしました。柔軟な高校生の時に、多様な価値観を持つ人々と交流することは、これから人種や民族を越えて協働していく社会において非常に重要なことだと思います。今後も、この様な機会を計画していきたいです。チャンスがあれば、ぜひSan Fsranciscoへ行き、Sacred Heart Cathedral Preparatory校に行ってみたいと思いました!

最後みんなで記念写真を撮りました
6月11日(水)応用数理科2年生ScienceEnglishの授業で羅東高級中学との課題研究のオンライン相互発表を行いました。5月に竹南高級中学とのオンライン発表を行っていましたので、その内容について先行研究などのScienceとしての要素増やし、発表を行いました。オンライン発表にも慣れてきてスムーズに発表できるようになってきました。羅当高級中学の発表については、研究が進んでおり、1年間研究した結果でした。海外でも同じように課題研究に取り組んでいること、英語でのプレゼンテーションがスタンダードであることなど、生徒にとっても非常によい経験になっているのではないでしょうか。海外の生徒のプレゼンテーション能力の高さには驚かされます。国民性などもあるかと思います。日本人の良さである丁寧に分かりやすく説明する力を十分に伸ばし、国際的に活躍できる人材育成に関わりたいと思います。


5月23日(金)午後から徳島文理大学薬学部を訪問し、ScienceIntroductionとして高大連携授業を行いました。担当していただく先生は、放射薬学研究室 の 張功幸 先生です。テーマは「蛍光物質を合成しよう」です。内容はフルオロセインなどの蛍光物質を化学反応にて合成し、合成した蛍光物質を紫外線に当て、励起状態とし、蛍光するさせる実験です。とても分かりやすい説明と実験手順でした。
実際の実験では濃硫酸を使用したり、オイルバスを利用したりし、生徒たちは「硫酸は何%かな?」や「温度の設定は?」など興味を持ちながら実験していました。最後に、紫外線を当て、蛍光を確認すると、とても美しい蛍光。生徒たちは、合成を行った化学物質が美しく発光する様子に感動していました。
実際に、体感すると現象の理解が進みます。まだ化学は未履修ですが、ぜひ興味関心を高め、化学の学習に繋げる機会にしてほしいと思いました。
![IMG_1583[1]](/file/4020)
![IMG_1597[1]](/file/4021)
本時の内容を確認します 蛍光物質を合成します
![IMG_1621[1]](/file/4022)
![IMG_1675[1]](/file/4024)
合成した蛍光物質に紫外線を当て、蛍光させます
![IMG_1682[1]](/file/4025)
最後に今日の実験内容を確認しました
5月22日(木)姉妹校である国立竹南高級中学 先生3名、生徒30名が海外研修として本校を訪問し、本校生徒と交流を行いました。
まず始めに全校生徒で歓迎会を行いました。



日本語・英語・中国語で 150周年の記念お土産をいただきました 両校の紹介を英語で
本校生徒が司会を行いました 行いました



本校ダンス部パフォーマンス お花のプレゼント 全員で記念写真
その後教室と実験室を実験室に移し、応用数理科2年生が英語での理科実験と知育菓子を使った交流を行いました。



酵素の実験です。胃腸薬でのデンプン分解と 知育菓子を使った交流です
カタラーゼの実験、ルミノール発光を観察しました。
午後からは、応用数理科3年生が交流し、英語で課題研究の発表を相互に行いました。



1年間取り組んできた課題研究の英語発表です お見送りしました
海外の同世代と交流することで生徒たちは非常に良い刺激になったと感じました。柔軟な高校生の時期に、多くの人と交流し、多様な感性を身に付けてほしいです。
なお、これらの交流は徳島新聞朝刊に掲載されました。

5月3日(土)9時から12時にかけて、毎年恒例のフィールドワークをしました。場所はいつもの吉野川市山川町高越山ふもとの川田川です。このイベントは城南高校主催で、県内の小・中学生とその保護者・家族を対象に、川原での鉱物採集を楽しむことを目的に実施しています。募集をかけたところ、締め切りを待たずに定員がいっぱいとなりました。ありがとうございます。
今年は天候が穏やかで、河川の増水もなく川原が広くなっていました。資料を配付してここで見つかる鉱物について説明し、荷物を背負ってポイントまで移動しました。この産地では30種類以上の鉱物や岩石が見つかっており、徳島県下では有数の鉱物産地です。特に人気なのが酸化チタンからなる金紅石(ルチル)やマントル起源のエクロジャイト、銅を多く含み青光りする斑銅鉱、石にはさまっているようなチタン石などです。参加者にはぜひ見つけて欲しいことを伝えました。
川が流れていた跡などがポイントです。ある小学生が青紫色の藍閃石片岩(青色片岩)をひっくり返すと、赤っぽい柱状結晶が現れました。ルチルです。これは珍しい。貴重な鉱物なので大事に持って帰るように伝えました。また、エクロジャイトもそれらしい石が見つかりました。他にもざくろ石やキースラーガー、緑レン石などがありました。成果としては充分です。
採集を終えてみんなで車座になって、石に鉱物名を書き込んでいきました。うちの高校生スタッフが大いに活躍しました。お疲れ様でした。次回は秋から冬にかけて計画中です。みなさんもまたぜひお越しください。
4月24日(木)日本時間11:00~12:00、本校応用数理科207HRと昨年度姉妹校提携を行った台湾国立竹南高級中学の生徒とオンライン交流を行いました。国立竹南高級中学は地域の進学校であり、理科教育に力を入れています。
Googlemeetを使い数グループでの交流を行いました。初めは、本校生徒と竹南高級中学の生徒がお互いに、自己紹介を行い、その後、課題研究のIntroductionパートのみ発表を行いました。発表内容は、今までのScienceIntroductionで、興味を惹くような質問を入れること、例えの話を入れることなど、相手に分かりやすく伝えるために必要なことを教えてくれ、面白いスライドが作成できていました。
発表や質疑はすべて英語で行いました。本校生徒は竹南高級中学の生徒達の英語力の高さに驚きながらも、しっかりと発表できたと思います。発表後にはインスタグラム等DMを交換し、早速交流を行っていました。
国立竹南高級中学は5月22日(木)に来校予定、12月の海外研修で訪問予定です。竹南高級中学の生徒はコミュニケーション能力が高く、生徒にとっては非常に良い体験になると感じています。
柔軟性のある高校時代に海を越えた同世代の生徒同士交流することでダイバーシティへの理解はもちろん、勉強や英語学習にお互い頑張っている姿を知ることで、学習意欲の向上につながる機会としたいと思います。


徳島県立城南高等学校にて 台湾国立竹南高級中学にて(竹南高級中学 先生から提供)
4月23日(水)207HRにて、理数探究のオリエンテーションを行いました。1年生の11月の課題研究研修会からテーマを磨いてきました。いよいよ本格的に課題研究の始まりです。
初めに、城南版実験ノートとポートフォリオの書き方と研究倫理、課題研究により身につく力について説明し、その後発表会等のスケジュールを確認しました。説明の後は、実験計画を担当と話したり、実際に実験開始したりしました。
今年度は、徳島文理大学と課題研究に関わる連携協定を結んでおり、大学と連携した発展的な課題研究が実施できるよう、取り組んでいきたいです。
城南高校の校風である自主自立の精神を生かした生徒の主体的なアイディアからの課題研究をモチベーション高く行うことで、多くの力を身に付けてほしいです。よい研究に導けるよう、我々も一緒に取り組んでいきます。


岐阜県西部の根尾谷は、菊花石という鑑賞石を産出することで有名です。黒い石の表面に放射状に伸びた白い結晶が浮かび上がり、それが菊の花のように見えることからそう呼ばれるようになりました。白い結晶を調べると主成分は炭酸カルシウムであり、結晶構造からそれは方解石の同質異像である霰(あられ)石とわかりました。
根尾谷では最近になって「さくら石」という鑑賞石が話題になりました。黄土色の母岩に赤色の桜または梅の花のような結晶が浮かんでいるものです。ちょうど阿南市の水井水銀鉱山の鉱石を分析するところだったので、これらをSEMで元素分析してみました。
結果は以下のとおりです。黄色がカルシウム、赤色が酸素、橙色がアルミニウムでした。岩石が赤いと酸化鉄をイメージするため、鉄が含まれていると考えてしまいます。しかし、このさくら石には鉄がほとんどなくアルミニウムが多いことがわかりました。確かにアルミニウム原料のボーキサイトも赤い石や土です。水井の赤い石も同様の結果となり、こちらにも水銀が含まれていませんでした。

一般の化学実験では分析できませんが、機器を選んでそれを利用すると短時間で正確に測定することができます。生徒たちに感想を尋ねると「分析が楽しくなってきた」、「高価な機器を使わせてもらい感動している」、「操作が思ったより簡単だった」、「この機器が欲しい」など好意的な返事が返ってきました。今後も続けていきたいです。
4月18日(金)5限目応用数理科1年生(107HR)で、Science Introductionのオリエンテーションを実施しました。
ScienceIntroductionでは、基礎実験や高大連携授業、課題研究のアプローチを行っていきます。これから始まる「実際に見て、触れて、体感して得られる学び」を体験してもらいたいです。
後半は、探究活動として、コインを重ねて落とした時に裏返る現象ついて、どのほうな法則なのか分析してもらいました。
一生懸命考え、法則を見つけたため、授業後には多くの生徒が質問に来たり、ディカッションをしたりしていました。考えたり、議論する面白さを知ってほしいです。
身近な現象をよく観察し、法則や原理を見つけ、考察を得る。主体的で深い学びは本当に面白いものであることを、少しでも理解してもらったらと思います。応用数理科での学びにより、探究する喜びを見いだし、思考力や想像力を高められるよう教材開発とサポートに取り組んでいきたいです。